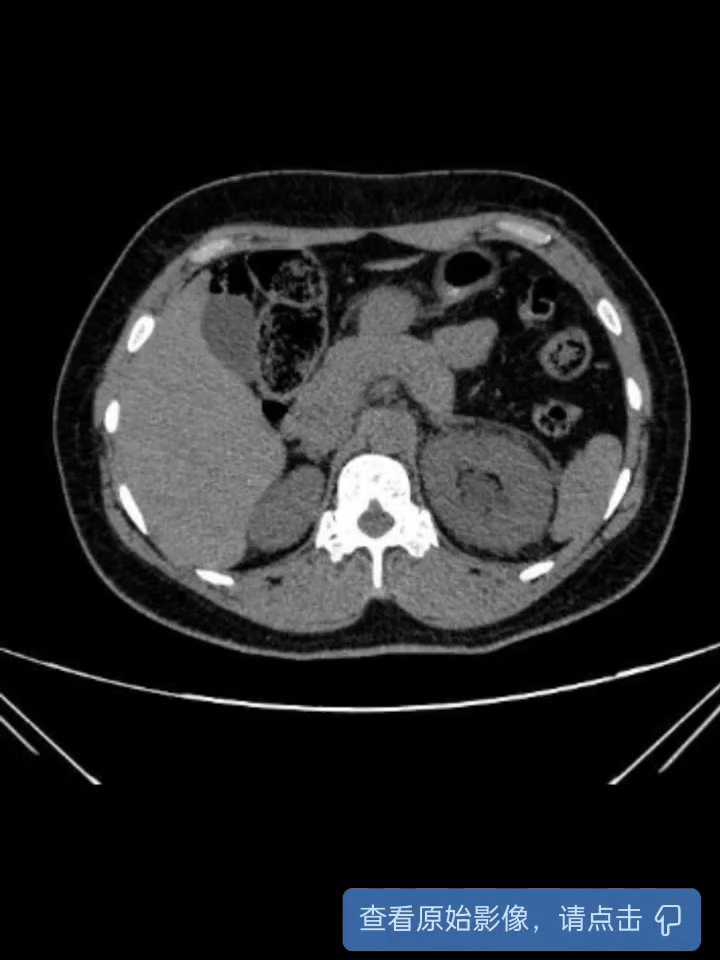
preview

输尿管镜碎石术~重复肾盂输尿管畸形
病例信息
【患者信息】:Ljz,女性,39岁
【主诉】:左侧腰腹部疼痛3小时
【现病史及既往史】: 3小时前患者无明显诱因出现左侧腰腹部胀痛,呈间歇性胀痛,难以忍受,遂由家属送至急诊科,完善下腹部CT平扫、盆腔CT平扫提示:左输尿管下段结石并以上输尿管、左肾轻度积水,左肾周渗出。并予对症解痉、止痛治疗后上述症状逐渐好转。门诊以“左侧输尿管结石并肾积水和感染”收住院治疗。
【检查】:肾区:双肾区无隆起,双肾区未扪及肿块,双合诊未触及双肾下极,左侧肋脊角压痛,右侧肋脊角无压痛,左肾区叩痛,右肾区无明显叩痛,双肾未闻及血管杂音;输尿管区:左侧输尿管走形区深压痛,右侧输尿管走行区无明显压痛。
术前CT:

【临床诊断】:1.左侧输尿管结石并肾积水;2.左侧重复肾盂输尿管畸形。
【治疗经过及结果】:入院后完善术前检查无明显手术禁忌症,次日行经尿道输尿管镜碎石术,术中证实左侧重复肾盂输尿管畸形,镜检两条输尿管均通常,分别两条通道置管。


术后复查CT:


病例讨论
术前比较担心其中有一条输尿管开口汇合处有狭窄,结石上移后可能无法进一步处理结石,所幸两处开口通过性尚可,但有一条类似于侧端汇入。
















































